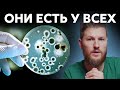

КАК ОБЪЕДИНИТЬ ФАЙЛЫ ЭКСЕЛЬ В ОДИН ФАЙЛ НА РАЗНЫЕ ЛИСТЫ
Как объединить файлы Excel в один файл на разные листы? Если у вас есть несколько файлов Excel с данными, которые нужно объединить в один файл, но на разных листах, этот процесс может быть легко выполнен. В этой статье мы рассмотрим несколько способов объединения файлов Excel и создания разных листов для каждого файла. Воспользуйтесь этими простыми шагами, чтобы быстро и эффективно объединить ваши файлы Excel.
Power Query. Как собрать несколько файлов Excel в один
Как объединить файлы эксель в один файл на разные листы:
Шаг 1: Откройте первый файл Excel.
Шаг 2: Выберите вкладку "Вставка" в меню верхней панели.
Шаг 3: Нажмите на кнопку "Лист из файла" или "Объединить" (в зависимости от версии Excel).
Шаг 4: В открывшемся окне, выберите второй файл, который вы хотите объединить.
Шаг 5: Укажите, на каком листе первого файла следует разместить данные из второго файла.
Шаг 6: Повторите шаги 2-5 для всех файлов, которые хотите объединить на отдельные листы.
Шаг 7: Нажмите "ОК" или "Применить", чтобы завершить процесс объединения файлов.
Шаг 8: Повторите шаги 1-7 при необходимости для любых других файлов, которые нужно объединить.
После завершения этих шагов, вы создадите новый файл Excel, в котором данные из разных файлов будут находиться на отдельных листах.
Как Объединить Два Файла в Один Excel ► Как Объединить Несколько Файлов Эксель в Один
Как объединить файлы Excel в один файл на разные листы – это важный вопрос для тех, кто работает с большим количеством данных и хочет сохранить их в удобной форме. Для этого можно воспользоваться функцией "Сводка" в Excel. Сначала необходимо открыть первый файл Excel, затем выбрать место на листе, где хотите разместить данные из второго файла. Затем выберите вкладку "Данные" и нажмите "Из другого источника". В появившемся окне выберите файл, который вы хотите объединить, и нажмите "Открыть". После этого выберите "Объединить в одну ячейку".
Затем повторите эти действия для остальных файлов, выбирая место на листе для их размещения. После завершения этой процедуры у вас будет один файл Excel с разными листами, содержащими данные из всех объединенных файлов. Таким образом, вы сможете легко организовать и анализировать свои данные.
Объединение файлов Excel в один файл на разные листы позволяет сэкономить время и упростить работу с данными. Благодаря этой функции вы можете легко сравнивать и комбинировать данные из разных источников, что может быть особенно полезно при работе с большими объемами информации. Используйте эту возможность, чтобы эффективно управлять своими данными и повысить продуктивность вашей работы в Excel.
Сборка таблиц из разных файлов Excel c помощью Power Query
Как объединить несколько файлов в один
Как объединить листы в Еxcel в один
Как несколько файлов эксель объединить в один
Сборка данных со всех листов книги
Сборка таблиц из разных файлов Excel